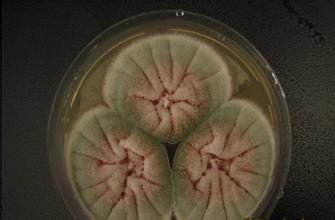

美国将送真菌上太空以研发新药
2016-04-01来源:厚朴方舟
3月28日,美国南加州大学宣布,该校科学家将与美国航天局喷气推进实验室的同行合作,把构巢曲霉这种真菌送到国际空间站,以便研发新药。
该校在一份声明中说,按计划,4月8日从美国卡纳维拉尔角发射的"龙"飞船将运送实验用的构巢曲霉至国际空间站。在太空高辐射、微重力的环境下,一些真菌将产生次级代谢物。次级代谢物不仅对真菌自身生长繁殖起到重要作用,还可以用于制药。青霉素等抗生素就是次级代谢物,它在细菌、真菌或其他微生物的繁殖过程中产生,能够杀灭或抑制其他微生物。
这已经不是美国前列次利用真菌科技创新了,早在2014年11月,美国已经用菌丝体的材料制造了首架"活"无人机,菌丝体是真菌的营养体,由许多菌丝聚集在一起组成。无人机广泛应用在军方侦察、信息采集和环境监测等领域,不过,倘若意外坠毁,留下的残骸不仅可能给某些敏感的环境造成污染,也是在告诉对方"你被盯住了"。但此架无人机或许能够避免这些问题,因为它在降解后,就变成了一小洼黏液。没人知道这到底是糖水洒了留下的痕迹,还是原本有一架飞机。
科学家不仅会把微生物带到太空培养,还会对国际空间站的微生物进行研究。2015年,来自美国和瑞典的一支联合科学家小组使用先进的分子分析技能,对国际空间站的微生物环境进行了勘测,结果证实与人类皮肤相关的特殊细菌大量存在于国际空间站的微生物菌群。
真菌被送上太空,利用太空高辐射、微重力的环境刺激真菌产生次级代谢物以研发新药。科学家是看中了太空这个特异的环境,将构巢曲霉进行天然的培养,科学家利用太空进行科学研究却不仅仅在真菌的培养上。
科学家利用太空这一特殊环境促进科学探索,研究生物在此环境中的改变,以至于给人类带来利益。太空确是一个神奇的地方,我们对它还不甚了解,也许它的神奇之处就是给我们无限期待。
厚朴方舟2012年进入海外医疗领域,总部位于北京,建立了由全球权威医学专家组成的美日名医集团,初个拥有日本政府官方颁发的海外医疗资格的企业。如果您有海外就医的需要,请拨打免费热线400-086-8008进行咨询!
本文由厚朴方舟编译,版权归厚朴方舟所有,转载或引用本网版权所有之内容须注明"转自厚朴方舟官网(www.hopenoah.com)"字样,对不遵守本声明或其他违法、恶意使用本网内容者,本网保留追究其法律责任的权利。
上一篇:乳腺X线片不仅仅能查乳腺,还有意外发现...... 下一篇:FDA批准无线心脏起搏器,心脏病治疗有大突破
相关推荐
厚朴方舟
厚朴方舟出国看病机构是中国企业初个拥有日本政府颁发的国际医疗从业资格证的公司,多年来整合了全球权威医疗资源,一直致力于打造“以患者为中心”的专业就医服务平台。公司在北京,上海,日本,美国均有分公司,为客户提供一站式海外就医服务。
咨询热线:400-086-8008
互联网药品信息服务资格证书编号:
(京)·非经营性·2015·0179
厚朴方舟健康管理(北京)有限公司 版权所有 www.hopenoah.com
京ICP备15061794号 京公网安备 11010502027115号